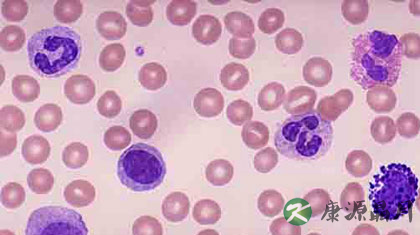
白细胞正常值范围是多少

小编导读:白细胞正常值范围是多少?白细胞是人体的“白色卫士”,白细胞数减少,就会削弱人体抗菌能力,容易受感染。那么白细胞正常值范围是多少?下面一起来看看吧。
白细胞正常值范围是多少
白细胞无色呈球形,有细胞核,体积比红细胞大,直径在7~20μm之间。血涂片中白细胞,经复合染料染色后,可根据其形态差异和细胞质内有无特有的颗粒可分为两大类五种细胞[颗粒白细胞(包括嗜酸性粒细胞、嗜碱性粒细胞、中性粒细胞)与无颗粒白细胞(包括淋巴细胞、单核细胞)]。
正常人的血细胞数目是4000-10000/μL(微升),其中中性粒细胞占0.50~0.70,嗜酸性粒细胞占0.005~0.05,嗜碱性粒细胞占0.005~0.01,单核细胞占0.03~0.08,淋巴细胞占0.20~0.40。
每日不同的时间和机体不同的功能状态下,白细胞在血液中的数目是有较大范围变化的。当每微升超过10000个时,称为白细胞增多;而每微升少于4000个时,则称为白细胞减少。有炎症时,血中的白细胞数明显增加。各类白细胞的防御保护作用各不相同。

说到白细胞的变化首先是数量的变化。正常人白细胞总数在(4.0~10.0)×10^9/L。其实在这个数值上下0.5×10^9/L,也可考虑大致正常,因为这和人们的个体差异有一定关系。成年男女一般都在这个范围内,且性别之间没有太大不同,但是儿童和婴幼儿则完全不同。新生儿出生时白细胞数量可达到(15~20)×10^9/L,在随后的一周中可降至15×10^9/L左右,在2岁以内可达到(10~12)×10^9/L,在5岁以下儿童也往往高于成人水平,平均值在8×10^9/L左右,以后随着年龄的长大,逐渐接近成人水平。
1、单位:个/升(个/L)
2、正常值范围:(单位为10个/L)
⑴成人为(4.0-10.0)×10^9个/L
⑵新生儿为(15-20)×10^9个/L
⑶6个月到2岁为(11-12)×10^9个/L
⑷4到14岁为8×10^9个/L
⑸儿童(5.0-12.0)×10^9/L
当白细胞数量低于4×10^9/L时被称为白细胞减少,但其临界值往往设定为(2.5~4)×10^9/L,也就是说低于2.5时肯定考虑为异常。白细胞数量明显减少也是不可忽视的问题,长期接触放射线、各种理化因素导致的中毒、肿瘤的化疗和放疗、脾功能亢进、自身免疫病、再生障碍性贫血、造血功能障碍等都会导致白细胞特别是中性粒细胞减少,当然这些疾病的诊断还要依靠其他的检查手段才能确定。
文章导语有说白细胞是人体的“白色卫士”,那么白细胞的功能作用有哪些呢?白细胞的功能作用,下面一起来看看。
白细胞的功能作用
白细胞能吞噬异物,浆细胞产生抗体,在机体损伤治愈、抗御病原的入侵和对疾病的免疫方面起着重要的作用。
机体发生炎症或其他疾病都可引起白细胞总数及各种白细胞的百分比发生变化,因此检查白细胞总数及白细胞分类计数成为辅助诊断的一种重要方法。
白细胞是一个庞大的血细胞家族,它们的形态结构和生理功能是多样的,但是,它们之间不是相互孤立的,在机体的防护、免疫和创伤愈治过程中起协同作用。尽管它们是血液中的一类细胞成分,但它们功能的发挥,更多地体现在循环管道外的器官组织中。在功能方面它们与这些器官组织中的许多细胞成分如巨噬细胞、肥大细胞、成纤维细胞等密切相关。
白细胞是机体防御系统的一个重要组成部分。它通过吞噬和产生抗体等方式来抵御和消灭入侵的病原微生物。
当白细胞数量明显减少,特别是中性粒细胞低于1.0×10^9/L时,非常容易发生感染、反复感染,且疾病治愈较为缓慢,甚至可以引发败血症,此时一定要引起患者本人和临床医师的高度重视。
豫公网安备 41110202000246号互联网药品信息服务资格证书:(豫)-经营性-2022-0039增值电信业务经营许可证:豫B2-20221313医疗器械经营备案编号:豫郑食药监械经营备20212188号



